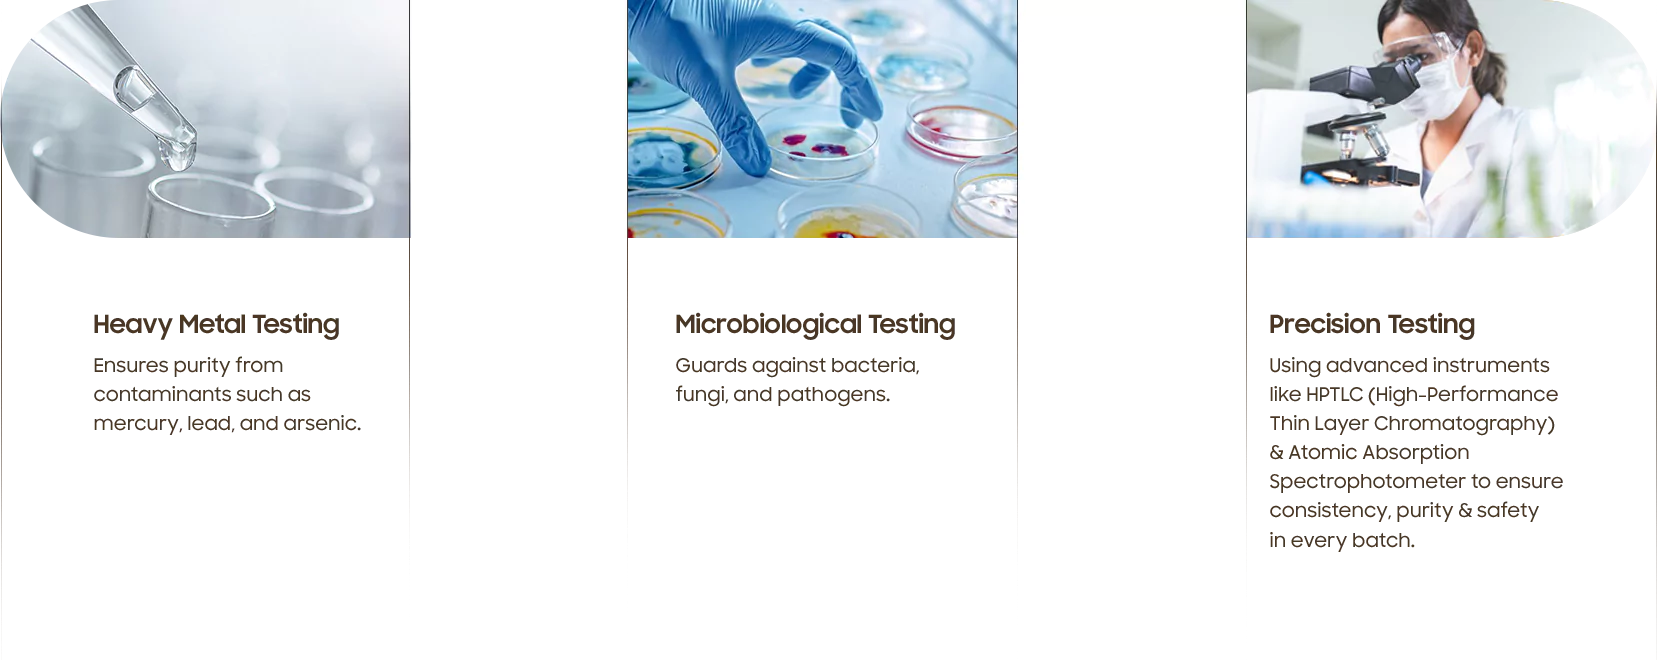

Ingredient Spotlight

Brahmi
Traditionally used to aid in calming the mind and may support mental clarity.*

Ashwagandha
Known for supporting stress management and may aid in immune function.*

Jatamansi
Traditionally used to help manage the nervous system and may promote deep relaxation.*
Related Herbs
Clinically Proven,
Ayurvedically Crafted
50%
86%
28%
SiddhaVeda Legacy:
A Healing Lineage


Quality Assurance & Testing
FAQ Section:
Your Questions, Answered
Become an Affiliate Partner






